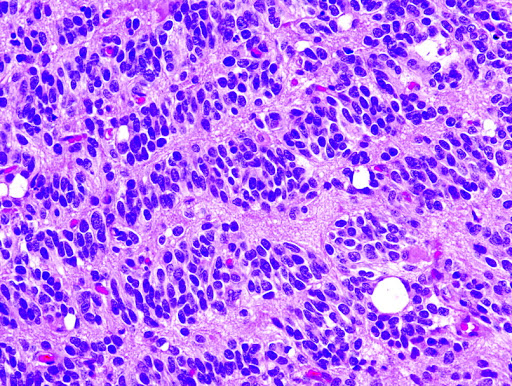
Orange

© 2021. All rights reserved.
 Hi, I’m a second year student pursuing my Masters in Computer Science at the Rochester Institute of Technology. By passion I am an engineer and my motto is Never Stop Learning. I like to develop products that can empower everyone to achieve more. My interests are in developing intelligent systems and I believe the world needs engineers like me in order to solve complex problems that human brain alone cannot solve.
Hi, I’m a second year student pursuing my Masters in Computer Science at the Rochester Institute of Technology. By passion I am an engineer and my motto is Never Stop Learning. I like to develop products that can empower everyone to achieve more. My interests are in developing intelligent systems and I believe the world needs engineers like me in order to solve complex problems that human brain alone cannot solve.
During my Bachelors at Indian Institute of Technology Jodhpur I got exposure to Data Structures and Algorithms and my first program of printing hello world has made me enthusiastic in writing more code and made me what i am today. After coming to RIT I have enhanced my programming skills by taking up the course on Algorithms and also by writing complex algorithms like heuristic search to my first Decision tree as part of the course on Artificial Intelligence.
I have also worked on diversifying my knowledge and skill set by taking up the courses such as Foundations of Computer Vision, Introduction to Machine Learning and loved every bit of developing projects such as Nuclei Segmentation and a feed forward neural network classifier to classify digits. I am also a Teaching Assistant for undergraduate courses on Java and Python and I mentor students by guiding them to use appropriate data structure and algorithms in their assignments and projects.
Prior to joining RIT for my masters I have almost 2.5 years of professional software development experience. During this time I have programmed in languages like Java, JavaScript and worked on different frameworks, projects and teams. As a software engineer I was responsible for designing and developing features for the product and also was part of some of the major refactorings of the code base. This experience gave me a valuable insight in system design and full stack development.
May 2021 - Aug 2021
Responsible for handling MATLAB App Building figure position while adding custom menu and tool bars in the figure. Documented use cases for the feature in confluence, designed architecture by learning solid architecture principles and implemented the design using JavaScript.Tracked the progress using Jira and used Perforce as version control software for the code.
Aug 2020 - May 2021
Taught Java and Python for over 100 students in their first year of undergrad and also mentored students to guide them in using appropriate Datastructures and Algorithms for their labs and projects.
Nov 2016 - Aug 2019
Worked as a developer for a web application product analogous to Tableau and was responsible for handling entire backend modules in the product. Designed and developed a lot of API's to ensure smooth flow and reduced the latency from ~8sec to ~2sec for the data to be extracted and visualized in the product. Led some major refactoring efforts for the codebases and reduced a lot of bugs.

Solved sudoku puzzle in live videos by leveraging functions in OpenCV as well as CNN for identifying digitis in the frame and finally using backtracking solved and displayed the result.
Segmented the tiny nuclei in the histopathological images by using a sophisticated voting algorithm to find markers and then applying the Marked Watershed algorithm on top of them using MATLAB.

Created a decision tree classifier using Python based on entropy and information gain to classify english and dutch language based on 10 handpicked features.Achieved an accuracy of 98% on 2000 sentences.

Implemented Apriori algorithm in Python to determine common mixed cuisines that go together in popular states in the US from Yelp Dataset to help investors/chefs to invest in those cuisines.